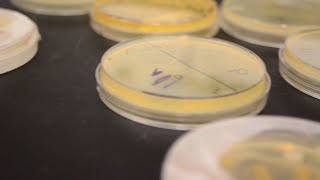

Student Research: Biology and Art video
Online izle ve mp4 mp3 formatlarinda yukle

Videonun muddeti: 5:15
Student Research: Biology and Art videosu mp4 ve mp3 yuklemek ucun hazirdir
Diqqet! Siz Mp4 yukle ve ya Mp3 yukle duymesine basdiqdan sonra eger sistem sizi reklam sehifesine atarsa o zaman derhal geri qayidib emeliyyati tekrar edin ve faylin yuklemek ucun hazir olmasini gozleyin
Videodan Mp4 Yukle
Videodan Mp3 Yukle-1
Videodan Mp3 Yukle-2
Oxshar Axtarishlar
 Student Research: Biology and Art
Student Research: Biology and Art Student Research in the Biology Department
Student Research in the Biology Department Student Research (Biology department)
Student Research (Biology department) Biology and Liberal Arts
Biology and Liberal Arts ASCB Outreach Grants Help Students Create Cell Biology-Inspired Art
ASCB Outreach Grants Help Students Create Cell Biology-Inspired Art First-year Biology Students Conduct Meaningful Research
First-year Biology Students Conduct Meaningful Research Heidi Hehnly, The Art of Science | Syracuse University Research
Heidi Hehnly, The Art of Science | Syracuse University Research Art integrated project of biology and science
Art integrated project of biology and science 12th Arts के बाद Medical Courses | Medical Courses After 12th Arts | 12th Arts Ke Baad Kya Kare
12th Arts के बाद Medical Courses | Medical Courses After 12th Arts | 12th Arts Ke Baad Kya Kare
Video Mp4 Mp3Azwap.Biz
Azwap.Biz 2021-2023

Student Research: Biology and Art
Student Research: Biology and Art Student Research in the Biology Department
Student Research in the Biology Department Student Research (Biology department)
Student Research (Biology department) Biology and Liberal Arts
Biology and Liberal Arts ASCB Outreach Grants Help Students Create Cell Biology-Inspired Art
ASCB Outreach Grants Help Students Create Cell Biology-Inspired Art First-year Biology Students Conduct Meaningful Research
First-year Biology Students Conduct Meaningful Research Heidi Hehnly, The Art of Science | Syracuse University Research
Heidi Hehnly, The Art of Science | Syracuse University Research Art integrated project of biology and science
Art integrated project of biology and science 12th Arts के बाद Medical Courses | Medical Courses After 12th Arts | 12th Arts Ke Baad Kya Kare
12th Arts के बाद Medical Courses | Medical Courses After 12th Arts | 12th Arts Ke Baad Kya Kare